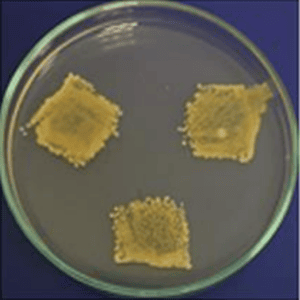
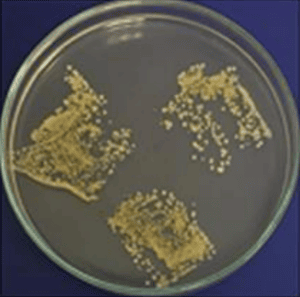
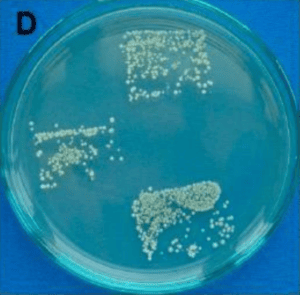
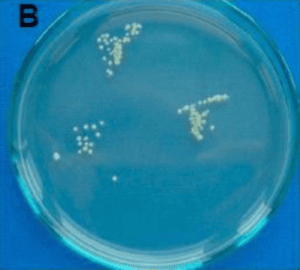
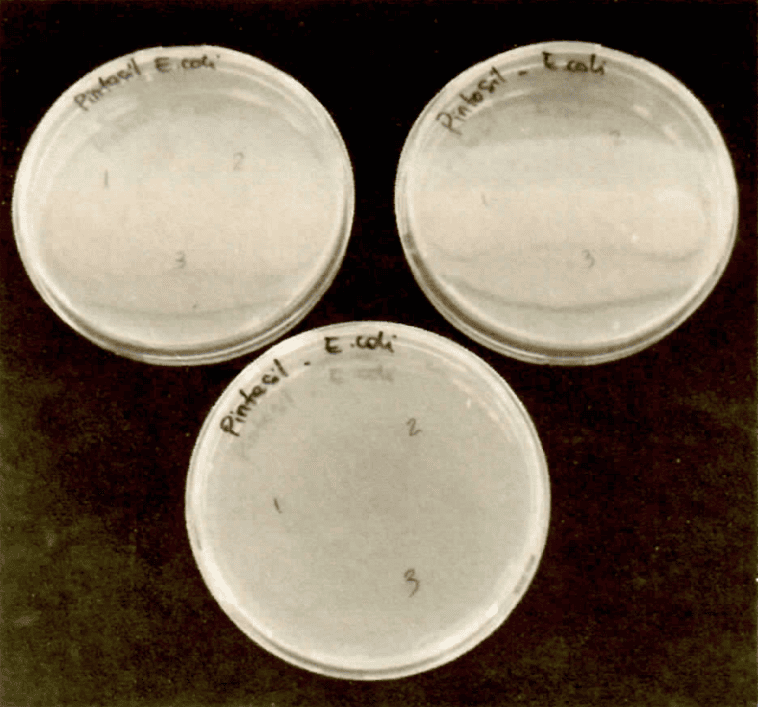
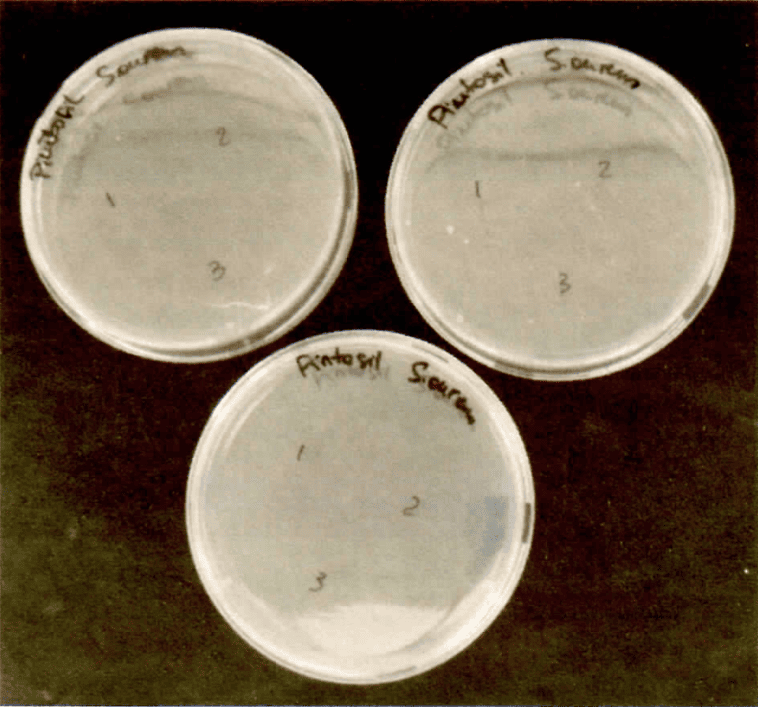

Se pintaron muestras en placas Petri de 25 mm cuadrados con dos capas de pintura PINTASIL, aplicadas en direcciones perpendiculares y con una diferencia de 24 horas. Después del periodo de secado, las muestras se desinfectaron con una lámpara germicida UV durante 30 minutos por lado.
Se inoculó cada muestra con una suspensión bacteriana estandarizada, utilizando Staphylococcus aureus y Escherichia coli. Las muestras se cubrieron con una lámina de polietileno desinfectada y se incubaron a 30 °C durante 24 horas con un 95% de humedad relativa.
Los valores de referencia utilizados para la interpretación de los resultados son los siguientes:
0: sin crecimiento;
1: cantidad detectable (colonia única);
2: cantidad detectable (colonias combinadas);
3: segunda impresión con colonias distinguibles y detección de la tercera huella o impresión;
4: tercera impresión con colonias distinguibles;
5: crecimiento excesivo y continuo hasta la tercera impresión.
A continuación, se presenta una imagen de referencia que ilustra una de las tres réplicas impresas para diferentes cepas bacterianas como ejemplo para facilitar la comprensión de los valores mencionados:
Valor = 5
Valor = 4

Valor = 0
Valor = 4
Valor = 2-3
En el caso del ensayo realizado con PINTASIL, se observó lo siguiente:

No se observó crecimiento de ninguna de las bacterias empleadas (S. aureus y E. coli) en ninguna de las placas incubadas a partir de la impresión de las muestras pintadas con PINTASIL, lo que corresponde al valor 0 en la escala de crecimiento utilizada como referencia.
Los resultados del ensayo realizado por el CIDEPINT en la Universidad Nacional de La Plata, Argentina, demuestran que las superficies pintadas con PINTASIL ejercen un efecto inhibitorio total sobre el crecimiento de Staphylococcus aureus y Escherichia coli. PINTASIL es una solución efectiva para prevenir la propagación de microorganismos en entornos donde la higiene es de suma importancia, como hospitales, laboratorios, espacios públicos, y también en residencias o casas, protegiendo la salud de los habitantes. Estos resultados prometedores sugieren que PINTASIL es una opción a tener en cuenta en la lucha contra la propagación de bacterias y la prevención de infecciones, beneficiando no solo a instituciones y espacios públicos, sino también a las familias en sus hogares.
Guillermo Barrios
Leonardo Otero
José Terra